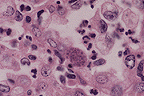

Supurative conjunctivitis with
epithelial hyperplasia in a guinea pig infected with Listeria
monocytogenes. (40X, HE, 95K)
Supurative conjunctivitis with
epithelial hyperplasia in a guinea pig infected with Listeria
monocytogenes. (40X, HE, 95K)
Signalment: Young hairless guinea pig, Cavia porcellus.
History: A shipment of guinea pigs was received from a commercial supplier and placed in quarantine. Five days after arrival, unilateral to bilateral ocular lesions ranging from serous lacrimation with hyperemic conjunctiva to purulent, ulcerative keratoconjunctivitis with neovascularization were observed in 11 guinea pigs. One guinea pig was euthanatized and necropsied.
Gross Pathology: Unilateral keratoconjunctivitis was observed.
Laboratory Results:
Complete Blood Count -- normal
Biochemical Profile -- normal.
Conjunctival Scraping -- negative for intracytoplasmic chlamydial
inclusions.
Conjunctival culture -- Listeria monocytogenes isolated.
Food, water and bedding material culture: negative.
Morphological Diagnosis: Eye: Keratoconjunctivitis, acute, diffuse, moderate with corneal erosion/ulceration, hemorrhage and gram positive intracellular bacterial rods.
Contributors Comments: No additional gross lesions were observed at necropsy. Histologically, the cornea was extensively ulcerated and exhibited stromal edema and vascular proliferation.
A diffuse, moderate to severe inflammatory infiltrate composed primarily of neutrophils with fewer numbers of lymphocytes and macrophages expanded the cornea and was present in the superficial bulbar and palpebral conjunctiva. The lacrimal gland had multifocal areas of necrosis and associated inflammatory cells. Some minimal, microscopic lesions were noted in other tissues but were deemed of no clinical significance.
Manifestations of listeriosis include meningoencephalitis, abortion and septicemia. Many fowl and most mammals, including man, are susceptible to this disease and generally present with one clinical form in naturally occurring cases (1). The causative agent is a small gram-positive, aerobic, nonspore-forming bacterium, Listeria monocytogenes. It is widely distributed in forage, silage, hay, water and mud (2). Isolates have been collected from many species including mammals, fowl, reptiles, amphibians, fish, mollusks, and arthropods (3).
The paucity of case reports of naturally acquired listeriosis in guinea pigs suggests that clinical disease is rare, despite the susceptibility of this species to experimental infection (3-6). This case is unusual in that it represents a primary, spontaneous keratoconjunctivitis associated with Listeria monocytogenes. Few reports of primary listerial conjunctivitis appear in the literature (1, 7-9). The clinical signs of conjunctivitis and endophthalmitis are not commonly seen and if present are generally observed in animals with listerial meningoencephalitis (1, 10).
AFIP Diagnosis: Eye and ocular adnexa: Keratoconjunctivitis, chronic-active, diffuse, moderate, with uveitis and corneal erosion and ulceration, guinea pig (Cavia porcellus), rodent.
Conference Note: While many conference attendees diagnosed the corneal inflammation as an acute or subacute process, we believe that the presence of hypertrophied fibroblasts within the corneal stroma and corneal neovascularization support classification of the inflammatory process as chronic-active. In addition to the keratoconjunctivitis, there is a uveitis characterized by scattered neutrophils and macrophages within the iris and choroid. Gram stains reveal rare gram-positive bacilli within superficial conjunctival epithelial cells.
The differential diagnosis for keratoconjunctivitis in the guinea pig includes Chlamydia psittaci, Micrococcus spp., Staphylococcus aureus, Pasteurella multocida, Bordetella bronchiseptica, and Proteus spp.
Contributor: USAMRICD MCRC-UV-YC Aberdeen Proving Ground, Maryland 21010-5425.
References:
International Veterinary Pathology Slide Bank:
Laser disc frame #5262, 7478, 11774, 11777, 11780, 13112, 17044-7,
and 21487-8.
Signalment: 4-year-old male baboon, Papio sp.
History: Staggering has been observed for 8 days. Possible encephalitis.
Gross Pathology: None.
Laboratory Results: Positive viral isolation. No other significant findings.
Contributor's Diagnosis and Comments: Meningoencephalitis, nonsuppurative, multifocal, etiology Baboon Reovirus.
A spontaneous epizootic of meningoencephalomyelitis occurred in approximately eleven members of the Southwest Foundation for Biomedical Research's 3000 member baboon colony. The baboons generally developed progressive central nervous system (CNS) signs with final paraplegia and death. Clinical pathology was not remarkable and no significant gross lesions were seen at necropsy. Histopathology consistently showed a nonsuppurative meningoencephalomyelitis of all CNS tissues available for evaluation. A syncytium-inducing baboon reovirus (BRV) was isolated from all five baboons brains submitted for viral isolation. The BRV was compared to representative mammalian reoviruses, avian reoviruses and the Nelson Bay virus on the basis of electropherotype, protein profile, and antigenic similarity as measured by immune precipitation using homologous and heterologous antisera. Results indicate the BRV is similar to members of the genus Orthoreovirus, family Reoviridae and represents a novel syncytium-inducing mammalian reovirus. At present, little is known about the BRV epidemiology but early limited serologic data indicate the BRV is endemic to the baboon colony.
AFIP Diagnosis: Cerebrum, cerebellum, and brain stem: Meningoencephalitis, lymphoplasmacytic, multifocal, severe, with gliosis and neuronal degeneration, baboon (Papio sp.), non-human primate.
Conference Note: Within the family Reovirus there are three genera of importance in veterinary medicine; Orthoreovirus, Orbivirus, and Rotavirus. The genus Orbivirus includes the viruses responsible for bluetonge in sheep, cattle, and deer; epizootic hemorrhagic disease of deer; and African horse sickness. The rotaviruses cause enteritis in most animals including birds, fish, and mammals.
The genus Orthoreovirus includes hepatoencephalomyelitis virus of mice, the avian orthoreoviruses (which cause a variety of disease processes including arthritis, tenosynovitis, enteritis, myocarditis, and respiratory disease), and the Nelson Bay virus. Nelson Bay virus has been isolated in the wild only once, from heart blood in a flying fox. Orthoreoviruses are the only nonenveloped viruses known to induce syncytia. It has not been determined if the ability of these reoviruses to form syncytia contributes to their pathogenicity.
Although the baboon reovirus was isolated from five baboons, all suffering from meningoencephalomyelitis, its relationship to the central nervous system disease has not yet been determined. Research is presently underway to identify the natural reservoir for baboon reovirus and to determine its pathogenicity in other hosts.
Contributor: Southwest Foundation for Biomedical Research, West Loop 410 at Military Drive, P.O. Box 28147, San Antonio, TX 78228-0147.
References:
Signalment: A two-year-old male rhesus monkey (Macaca mulatta)
History: This monkey became hypoproteinemic, uremic, developed dependent edema and was euthanized in a moribund state.
Gross Pathology: Dependent subcutaneous edema, extensive edema throughout the gastrointestinal tract, ascites, kidneys pale and enlarged.
Laboratory Results: A blood sample prior to necropsy showed
the following clinical pathology test values:
Urinalysis: Proteinuria (>2000 mg/dL), hemoglobinuria
Morphologic Diagnosis & Etiology: Glomerulonephritis, membranoproliferative, subacute, moderate, diffuse, kidney, rhesus monkey (Macaca mulatta)
Contributor's Diagnosis and Comments: Light microscopy shows a section of kidney with numerous dilated tubules extending from the cortex to medulla. Many of these dilated tubules contain proteinaceous casts and are lined with attenuated epithelium. Numerous other tubules are lined with cuboidal proliferative epithelium. There are multifocal areas of minimal fibrosis with slight to moderate lymphocytic infiltrates. The majority of glomeruli have increased membranous component and are moderately hypercellular. Intravascular neutrophils and mononuclear cells were within the tufts. Multifocally the glomerular parietal epithelium is moderately hypertrophied.
Electron microscopic examination revealed abundant irregular granular sub-endothelial deposits characteristic of IgG and complement deposition of type I membranoproliferative glomerulonephritis. It was surprising to find such a marked renal lesion in such a young animal. A specific etiology or inciting factor for the lesion was not determined.
AFIP Diagnosis: 1. Kidney: Glomerulonephritis, membranoproliferative,
global, chronic, diffuse, severe, with crescent formation and
tubular proteinosis, degeneration and regeneration, rhesus monkey
(Macaca mulatta), nonhuman primate.
2. Kidney: Nephritis, interstitial, lymphoplasmacytic, chronic,
multifocal, moderate, with lymphoid follicle formation.
Conference Note: Membranoproliferative glomerulonephritis (MPGN) is caused by the concomitant deposition of immune complexes in glomeruli and activation of the complement pathway. The glomeruli are enlarged and hypercellular, due to proliferation of mesangial cells. The capillary loops often have a double contour appearance due to splitting of the basement membrane by cytoplasmic processes of mesangial cells, a process known as mesangial interposition. The parietal cells along Bowman's capsule are often hypertrophied and/or hyperplastic and may contribute to crescent formation. There often are inflammatory cells in the affected glomeruli.
There are three types of MPGN which are classified according to the location of the immune complex deposition. Type I MPGN refers to the formation of subendothelial immune complex deposits; this is the most common type. Type II MPGN is characterized by immune complex deposition in the basement membrane. Type III MPGN is rare and is characterized by subendothelial and subepithelial deposition of immune complexes.
Immune complex-induced glomerulonephritis is believed to be caused by circulating antigen-antibody complexes that localize in glomeruli. Alteratively, antigens may localize in the glomeruli and then bind antigen. In either case, the resulting complement activation leads to neutrophil recruitment, release of lysosomal enzymes and production of arachidonic acid and oxygen free radical metabolites, all of which further injure glomeruli. Similarly, complement can activate the coagulation cascade, thereby initiating coagulation, thrombosis and kinin-forming systems. Mesangial cells can also be stimulated to produce oxygen free radicals, interleukin-1, arachidonic acid metabolites and many different growth factors.
Many etiologic agents and conditions have been associated with immune-mediated glomerulonephritis in animals including canine adenovirus, feline leukemia virus, feline infectious peritonitis virus, equine infectious anemia virus, Borrelia burgdorferi, chronic pancreatitis, coccidiosis, Dirofilaria immitis and systemic lupus erythematosus. The cause in this case is not known.
Contributor: Corning Hazleton, P.O. Box 7545, Madison, WI 53707-7545.
References:
Signalment: Two-month-old male crossbred cat.
Interstitial pneumonia
with intracytoplasmic tachyzoites of Toxoplasma gondii
(40X, HE, 107K)
Interstitial pneumonia
with intracytoplasmic tachyzoites of Toxoplasma gondii
(40X, HE, 107K)
 Positive avidin-biotin immunohistochemical
procedure against T. gondii sporozoites.
Positive avidin-biotin immunohistochemical
procedure against T. gondii sporozoites.
History: The kitten was found dead by its owner. Neither clinical examination data nor laboratory results were available for this case, which was considered a sudden death.
Gross Pathology: The gross aspects of the lungs at necropsy were not described by the veterinarian who sent representative slices of this organ for histopathological examination.
Morphologic Diagnosis & Etiology: Subacute interstitial pneumonia, with "fetalization" of lung, and Toxoplasma gondii tachyzoites, two-month-old kitten.
Laboratory Results: N/A
Contributor's Diagnosis and Comments: The alveolar walls presented altered lining epithelial cells, which became cuboidal or columnar, acquiring the appearance of a fetal lung ("fetalization" of lung). The alveoli were filled with large mononuclear cells and leukocytes with aggregation of Toxoplasma gondii tachyzoites near and within the cytoplasm of the cells lining the alveoli. Toxoplasma gondii is a protozoan that infects several animal species and man. The cat is considered the definitive host of this parasite, which produces oocysts within the cat's intestine, which are infective after sporogeny. When exposed to cat feces, or contaminated materials or organs, most mammals, including cats and birds can serve as intermediate hosts. The placental transmission of tachyzoites has also been reported. Definitive and differential diagnosis of toxoplasmosis is often difficult. Clinically, it should be differentiated from other diseases that cause lymphadenopathy, fever, pneumonia, myocarditis, hepatitis, encephalitis, abortion or sterility and chorioretinitis. Serological tests for evaluation of anti-Toxoplasma antibody titers are indicated. At the histopathological level, Toxoplasma organisms should be differentiated from Sarcocystis, Trypanosoma cruzi, Besnoitia besnoitia, Hammondia hammondi, and sporozoites of coccidia. In the present case, immunohistochemistry (avidin-biotin technique) with monoclonal antibodies against Toxoplasma gondii was used to identify the tachyzoites. Toxoplasma infection may be associated with FIV or FeLV infection; these virus can be transmitted from mother to kitten probably after birth, and not transplacentally. It was not possible to perform serological virus examination in the present case.
AFIP Diagnosis: Lung: Pneumonia, interstitial, neutrophilic, histiocytic, and lymphoplasmacytic, diffuse, severe, with diffuse type II pneumocyte hyperplasia and numerous intracellular tachyzoites, cross-breed, feline.
Conference Note: Toxoplasma gondii is an obligate intracellular coccidian protozoa in the phylum Apicomplexa; this group includes Neospora, Hammondia, Besnoitia, Isospora, Sarcocystis, and Frankelia. Toxoplasmosis occurs worldwide and has a wide range of intermediate hosts; however, cats are the only definitive host for T. gondii.
Cats ingest sporulated oocysts or tissues infected with encysted bradyzoites (this is the most common source of infection) which excyst as bradyzoites. Bradyzoites begin an enteroepithelial cycle of asexual and sexual multiplication, followed by oocyst development and shedding of unsporulated oocysts in the feces. Oocysts sporulate outside the body and therefore are not immediately infective. Immunocompetent cats shed oocysts only once in their lifetime for a period of 7-10 days. In the definitive host, systemic infection occurs simultaneously with the intestinal infection.
Non-felid hosts ingest sporulated oocysts or tissues infected with tachyzoite filled cysts of T. gondii. Once ingested, the zoites excyst and multiply in the intestine and associated lymph nodes as tachyzoites. Tachyzoites multiply by endodyogeny (two progeny forming within a parent cell). After repeated replication cycles, the tachyzoites encyst in host tissue; most often cysts are found in nervous tissue, skeletal muscle, or myocardium. Cysts are thin-walled and contain anywhere from a few to several hundred bradyzoites. Transmission may also occur via transplacental infection in both felid and non-felid hosts.
Immunocompetent animals usually develop adequate immune responses to T. gondii a few days post-infection. Tachyzoites disappear from circulation, leaving dormant cysts within the brain, skeletal muscle, and myocardium. The encysted zoites are protected from both humoral and cellular immune systems. The cysts rupture and initiate systemic toxoplasmosis if the animal later becomes immunosuppressed, a common sequela in cats infected with feline immunodeficiency virus or feline leukemia virus and in people infected with human immunodeficiency virus.
Systemic toxoplasmosis occurs most frequently in marsupials, arboreal primates and immunocompromised animals. Common lesions of systemic toxoplasmosis are interstitial pneumonia, necrotizing hepatitis, lymphadenitis, myocarditis, and/or nonsuppurative meningoencephalitis.
Contributor: Faculty of Veterinary Medicine, University of Sao Paulo, Av. Corifeu de Azevedo marques, 2720, Sao Paulo, SP, 05610-900, BRAZIL.
References:
International Veterinary Pathology Slide Bank:
Laser disc frame #1125, 4901-3, 5089-91, 5667, 5901-3, 6662-3,
6917, 7203, 7215, 7238, 7265-6, 9001-8, 9099-101, 9129, 9136,
9361, 9648-51, 10444-6, 11169-79, 11181, 13671-2, 15216, 15949,
20951, 22144, 23265.
Dana P. Scott
Captain, VC, USA
Registry of Veterinary Pathology*
Department of Veterinary Pathology
Armed Forces Institute of Pathology
(202)782-2615; DSN: 662-2615
Internet: Scott@email.afip.osd.mil
* The American Veterinary Medical Association and the American College of Veterinary Pathologists are co-sponsors of the Registry of Veterinary Pathology. The C.L. Davis Foundation also provides substantial support for the Registry.